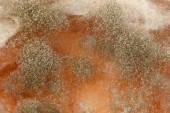

Spleśniałe jabłko. Forma i grzyby na owocach i warzywach

Informacje o pliku:
| Numer pliku: | 0101409798428 |
| Typ pliku/format: | Zdjęcia ( JPG ) |
| Rozdzielczość: | 4608x3456 (39,01x29,26 cm 300 dpi) |
| Kategorie: | |
| Autor: | kravaivan.11@gmail.com |